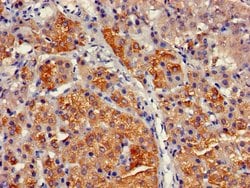
Invitrogen CYP17A1 Polyclonal Antibody 100 &mu;g | Buy Online | Invitrogen&trade; | Fisher Scientific

missing translation for 'onlineSavingsMsg'
Learn More
Learn More
Invitrogen™ CYP17A1 Polyclonal Antibody


Descripción
CYP17A1 Polyclonal Antibody for Western Blot, IHC (P), ICC/IF, ELISA
This gene encodes a member of the cytochrome P450 superfamily of enzymes. The cytochrome P450 proteins are monooxygenases which catalyze many reactions involved in drug metabolism and synthesis of cholesterol, steroids and other lipids. This protein localizes to the endoplasmic reticulum. It has both 17alpha-hydroxylase and 17,20-lyase activities and is a key enzyme in the steroidogenic pathway that produces progestins, mineralocorticoids, glucocorticoids, androgens, and estrogens. Mutations in this gene are associated with isolated steroid-17 alpha-hydroxylase deficiency, 17-alpha-hydroxylase/17,20-lyase deficiency, pseudohermaphroditism, and adrenal hyperplasia.

Especificaciones
Especificaciones
| Antígeno | CYP17A1 |
| Aplicaciones | ELISA, Immunohistochemistry (Paraffin), Western Blot, Immunocytochemistry |
| Clasificación | Polyclonal |
| Concentración | 4 mg/mL |
| Conjugado | Unconjugated |
| Formulación | PBS with 50% glycerol and 0.03% ProClin 300; pH 7.4 |
| génica | CYP17A1 |
| N.º de referencia del gen | P05093 |
| Alias de gen | 17a-hydroxylase; 17-alpha-hydroxyprogesterone aldolase; CPT7; Cyp17; Cyp17a1; CYPXVII; cytochrome P450 17A1; cytochrome P450 family 17 subfamily A member 1; cytochrome p450 XVIIA1; cytochrome P450, 17; cytochrome P450, 17a1; cytochrome P450, family 17, subfamily A, polypeptide 1; cytochrome P450, subfamily 17; Cytochrome P450, subfamily XVII; cytochrome P450, subfamily XVII (steroid 17-alpha-hydroxylase), adrenal hyperplasia; Cytochrome P450c17; cytochrome P450-C17; HGNC:2593; P45017alpha; p450c17; P450-C17; S17AH; steroid 17-alpha hydroxylase; steroid 17-alpha-hydroxylase/17,20 lyase; Steroid 17-alpha-monooxygenase |
| Símbolos de los genes | CYP17A1 |
| Mostrar más |
Título del producto
Al hacer clic en Enviar, acepta que Fisher Scientific se ponga en contacto con usted en relación con los comentarios que ha proporcionado en este formulario. No compartiremos su información para ningún otro fin. Toda la información de contacto proporcionada se mantendrá de acuerdo con nuestra Política de Privacidad. Política de privacidad.
¿Detecta una oportunidad de mejora?